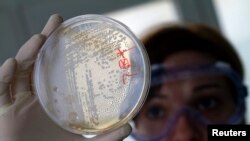
Tehničar u laboratoriji traži elemente bakterije ešerihija koli u ćelijama povrća.

Lekari odavno upozoravaju protiv prekomerne upotrebe antibiotika, ističući da bakterije mogu da steknu otpornost na lekove i na kraju ih učine nedelotvornim. Svetska zdravstvena organizacija saopštila je da bakterije otporne na antibiotike sada postoje u brojnim delovima sveta. Neke bolesti, koje je su bile izlečive pomoću antibiotika, sada su postale smrtonosne.
Svetska zdravstvena organizacija, sa sedištem u Ženevi, sapštila je da njen izveštaj pokazuje veoma visok nivo bakterije eširihije koli koja je otporna na lekove, koja može da izazove meningitis i infekciju kože, krvi, bubrega i drugih organa. Pomoćnik generalnog direktora agencije Keiđi Fukuda izjavio je da je istraživanje takođe pokazalo zabrinjavajući nivo otpornosti drugih bakterija, kao što su one koje izazivaju upalu pluća, dijareju, infekciju urinarnog trakta i gonoreju.
“Jasno je da je nivo otpornosti veoma visok među bakterijama koje uzrokuju većinu poznatih ozbiljnih infekcija, kako onih koje se pojavljuju u zajednicama, tako i onih u bolnicama.”
Rumunski lekar Adrijan Čerčel kaže da za neke od njegovih pacijenata bukvalno više nije bilo tretmana.
“Tokom poslednjih 20 godina, bakterije su razvile veoma sofisticirane odbrambene mehanizme i suočavamo se sa situacijom u kojoj nemamo antibiotike za tretiranje pacijenata kod kojih su ustanovljene otporne bakterije.”
U izveštaju SZO navodi se da u nekim zemljama brojne vrste bakterijskih infekcija ne reaguju na tretman antibioticima kod više od polovine pacijenata. Specijalisti za javno zdravlje okrivljuju prekomernu upotrebu antibiotika koji se često prepisuju za infekcije koje nisu bakterijske. Žan-Batist Rona iz organizacije Lekari bez granica kaže da ljudi često unose u organizam lekove nenamerno, konzumiranjem mesa od životinja koje su tretirane antibioticima.
“Dve najveće opasnosti su zapravo upotreba i prekomerna upotreba antibiotika u fabrikama hrane i gajenju životinja za ishranu, posebno činjenica da koristimo antibiotike kao faktor rasta već godinama u Sjedinjenim Državama i svuda u svetu. To je bilo ograničeno u Evropi od 2001. Drugi je prekomerna upotreba u zdravstvu ljudi. Uzimajući u obzir činjenicu da većinom, ljudi uzimaju antibiotike zbog obične prehlade i zato što jednostavno žele antibiotike.”
Rona i drugi kažu da se svet vraća u stanje slično onom pre pronalaska antibiotika.
“To znači u 19. vek, pre prvog svetskog rata, kada nismo imali antibiotike i kada se umiralo zbog infekcije urinarnog trakta ili pluća. To je ono što će se događati u budućnosti.”
Svetska zdravstvena organizacija opisuje problem kao glavnu pretnju globalnom zdravlju. Ona preporučuje ljudima da koriste antibiotike samo ako im je lekar to prepisao. Trebalo bi da završavaju punu prepisanu dozu antibiotika, da ih nikada ne dele sa drugima i ne koriste višak recepata.
Svetska zdravstvena organizacija, sa sedištem u Ženevi, sapštila je da njen izveštaj pokazuje veoma visok nivo bakterije eširihije koli koja je otporna na lekove, koja može da izazove meningitis i infekciju kože, krvi, bubrega i drugih organa. Pomoćnik generalnog direktora agencije Keiđi Fukuda izjavio je da je istraživanje takođe pokazalo zabrinjavajući nivo otpornosti drugih bakterija, kao što su one koje izazivaju upalu pluća, dijareju, infekciju urinarnog trakta i gonoreju.
“Jasno je da je nivo otpornosti veoma visok među bakterijama koje uzrokuju većinu poznatih ozbiljnih infekcija, kako onih koje se pojavljuju u zajednicama, tako i onih u bolnicama.”
Rumunski lekar Adrijan Čerčel kaže da za neke od njegovih pacijenata bukvalno više nije bilo tretmana.
“Tokom poslednjih 20 godina, bakterije su razvile veoma sofisticirane odbrambene mehanizme i suočavamo se sa situacijom u kojoj nemamo antibiotike za tretiranje pacijenata kod kojih su ustanovljene otporne bakterije.”
U izveštaju SZO navodi se da u nekim zemljama brojne vrste bakterijskih infekcija ne reaguju na tretman antibioticima kod više od polovine pacijenata. Specijalisti za javno zdravlje okrivljuju prekomernu upotrebu antibiotika koji se često prepisuju za infekcije koje nisu bakterijske. Žan-Batist Rona iz organizacije Lekari bez granica kaže da ljudi često unose u organizam lekove nenamerno, konzumiranjem mesa od životinja koje su tretirane antibioticima.
“Dve najveće opasnosti su zapravo upotreba i prekomerna upotreba antibiotika u fabrikama hrane i gajenju životinja za ishranu, posebno činjenica da koristimo antibiotike kao faktor rasta već godinama u Sjedinjenim Državama i svuda u svetu. To je bilo ograničeno u Evropi od 2001. Drugi je prekomerna upotreba u zdravstvu ljudi. Uzimajući u obzir činjenicu da većinom, ljudi uzimaju antibiotike zbog obične prehlade i zato što jednostavno žele antibiotike.”
Rona i drugi kažu da se svet vraća u stanje slično onom pre pronalaska antibiotika.
“To znači u 19. vek, pre prvog svetskog rata, kada nismo imali antibiotike i kada se umiralo zbog infekcije urinarnog trakta ili pluća. To je ono što će se događati u budućnosti.”
Svetska zdravstvena organizacija opisuje problem kao glavnu pretnju globalnom zdravlju. Ona preporučuje ljudima da koriste antibiotike samo ako im je lekar to prepisao. Trebalo bi da završavaju punu prepisanu dozu antibiotika, da ih nikada ne dele sa drugima i ne koriste višak recepata.